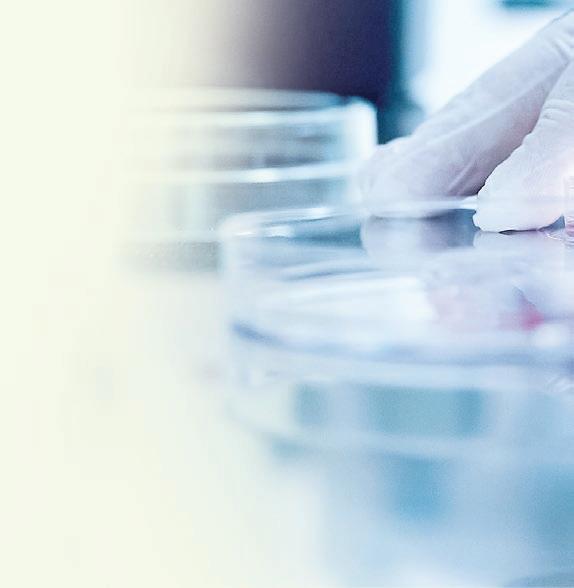

El 4 de Guanajuato es un periódico gratuito, editado y distribuido semanalmente por la Unidad de Televisión de Guanajuato. Calle Oaxaca No. 502 Col. Arbide C.P.36670 León, Guanajuato. Tel: 477 716 1820. Número de Certificado de Reserva otorgado por el Instituto Nacional de Derecho de Autor: en trámite. Año 2 Número 63.